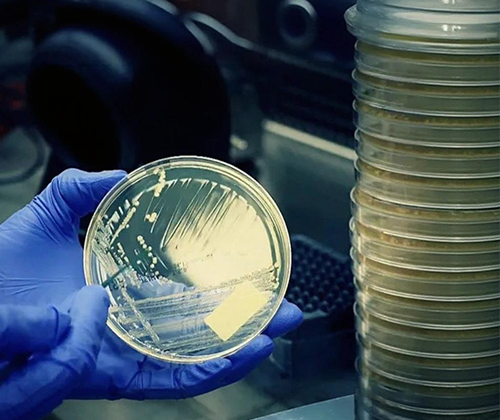
The Microbial Enumeration Test
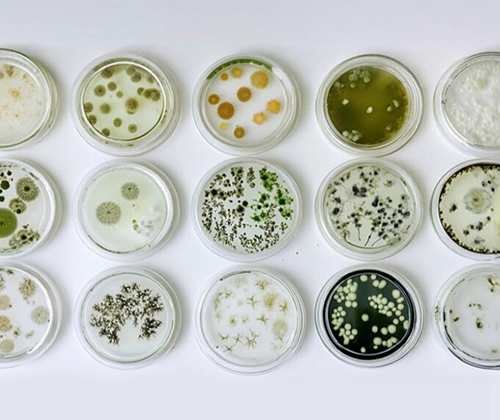
Microbial Identification
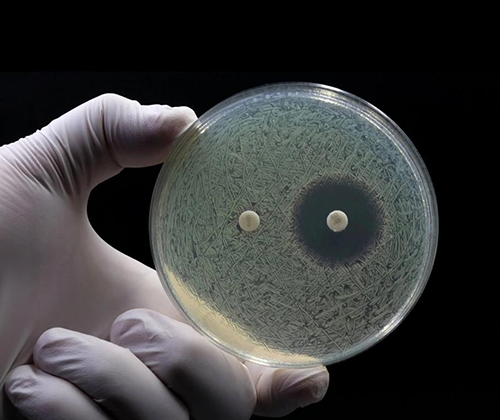
MIC and MBC/MFC Testing
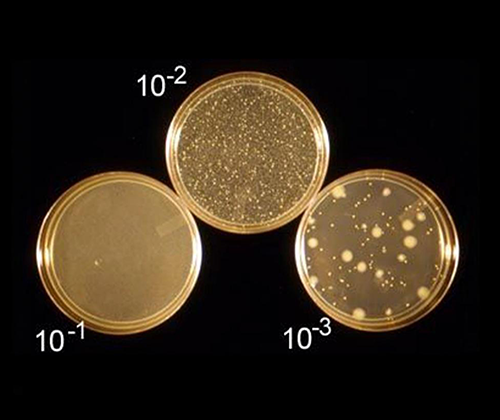
Killing Time Assay

Microbiological Assays
The Microbial Enumeration Test
The Microbial Enumeration Test is a crucial quantitative method used to det...
View Details
Microbial Identification
A microbial identification test is a laboratory procedure used to determine...
View Details
MIC and MBC/MFC Testing
Minimum Inhibitory Concentration (MIC) and Minimum Bactericidal/Fungic...
View Details
Anti-Biofilm Assay
An Anti-Biofilm Assay is used to evaluate the ability of a substance (e.g.,...
View Details_cover_1761231429.png)
Antimicrobial Effectiveness Testing (AET)
Preservatives are antimicrobial additives that are incorporated into product for...
View Details
Killing Time Assay
A Killing Time Assay is a test that measures the ability of an antimicrobia...
View Details